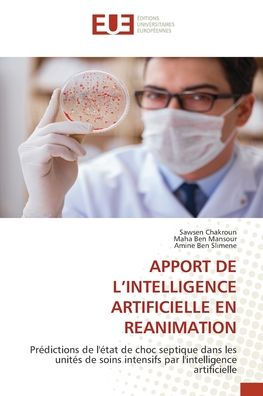
Apport de l'Intelligence Artificielle En Reanimation

Home
Project Reanimation: The Beginning
Barnes and Noble
Loading Inventory...
Project Reanimation: The Beginning in Chattanooga, TN
Current price: $10.00

Barnes and Noble
Project Reanimation: The Beginning in Chattanooga, TN
Current price: $10.00
Loading Inventory...
Size: OS
Dani will soon find out that this year will be a senior year in high school she will never forget.
Dani will soon find out that this year will be a senior year in high school she will never forget.
![Black Sky Over the Projects: Apartment 2025 [ Swirl Viny] [Barnes & Noble Exclusive]](https://prodimage.images-bn.com/pimages/0760137195047_p0_v1_s600x595.jpg)